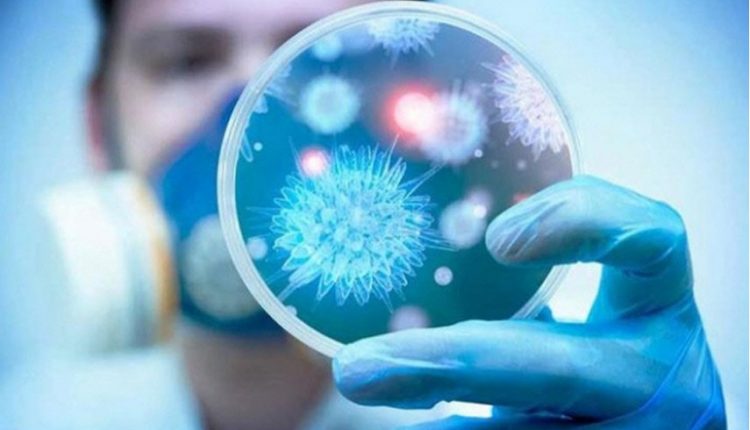

اصابة أول ممثلة سورية بكورونا!
وهج 24 : كشفت الفنانة السورية هناء نصور عن إصابتها بفيروس كورونا المستجد، معتبرة أن إعلانها واجب مقدس تجاه الآخرين.
وقالت نصور بحسب ما نشره موقع “مراسلون” السوري، إنها أصيبت بفيروس كورونا خلال زيارتها إلى البرازيل.
وبذلك تكون نصور أول فنانة سورية تعلن إصابتها بالفيروس الذي انتشر حول العالم منذ نهاية ديسمبر الماضي.
وأوضحت نصور أن صديقة لها برازيلية الجنسية تعلمها عزف البيانو، أصيبت بالفيروس ولم تكن تعلم، وبعد عشرة أيام اتصل زوج البرازيلية معلنا إصابتها وأن على نصور وصديقة سورية أخرى إجراء الفحوصات اللازمة.
وأعلنت وزارة الصحة السورية عن تسجيل 4 حالات إصابة جديدة بفيروس كورونا المستجد في البلاد ليرتفع العدد الإجمالي للإصابات إلى 9 حالات بالإضافة إلى حالة وفاة واحدة.
وأعلنت منظمة الصحة العالمية أمس الأحد، أن عدد الإصابات المسجلة بفيروس كورونا بلغ أكثر من 835 ألف إصابة في جميع أنحاء العالم، بينما بلغ عدد الوفيات حوالي 30 ألف شخص.
المصدر : وكالات